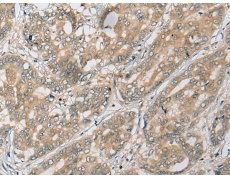
一抗

中文名稱:兔抗ADAP1多克隆抗體
|
Background: |
GTPase-activating protein for the ADP ribosylation factor family (Probable). Binds phosphatidylinositol 3,4,5-trisphosphate (PtdInsP3) and inositol 1,3,4,5-tetrakisphosphate (InsP4). |
|
Applications: |
ELISA, IHC |
|
Name of antibody: |
ADAP1 |
|
Immunogen: |
Fusion protein of human ADAP1 |
|
Full name: |
ArfGAP with dual PH domains 1 |
|
Synonyms: |
GCS1L; CENTA1; p42IP4 |
|
SwissProt: |
O75689 |
|
ELISA Recommended dilution: |
5000-10000 |
|
IHC positive control: |
Human liver cancer and Human thyroid cancer |
|
IHC Recommend dilution: |
25-100 |


 購(gòu)物車
購(gòu)物車 幫助
幫助
 021-54845833/15800441009
021-54845833/15800441009